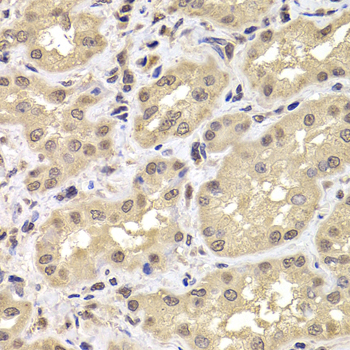
Immunohistochemistry - PSMD12 Polyclonal Antibody

-
Product Name
PSMD12 Polyclonal Antibody
- Documents
-
Description
Polyclonal antibody to PSMD12
-
Tested applications
WB, IHC
-
Species reactivity
Human, Mouse, Rat
-
Alternative names
PSMD12 antibody; Rpn5 antibody; p55 antibody; STISS antibody; proteasome 26S subunit, non-ATPase 12 antibody
-
Isotype
Rabbit IgG
-
Preparation
Antigen: Recombinant fusion protein containing a sequence corresponding to amino acids 197-456 of human PSMD12 (NP_002807.1).
-
Clonality
Polyclonal
-
Formulation
PBS with 0.02% sodium azide, 50% glycerol, pH7.3.
-
Storage instructions
Store at -20℃. Avoid freeze / thaw cycles.
-
Applications
WB 1:500 - 1:2000
IHC 1:50 - 1:200 -
Validations

Western blot - PSMD12 Polyclonal Antibody
Western blot analysis of extracts of various cell lines, using PSMD12 antibody at 1:1000 dilution.Secondary antibody: HRP Goat Anti-Rabbit IgG (H+L) at 1:10000 dilution.Lysates/proteins: 25ug per lane.Blocking buffer: 3% nonfat dry milk in TBST.Detection: ECL Basic Kit .Exposure time: 90s.
Immunohistochemistry - PSMD12 Polyclonal Antibody
Immunohistochemistry of paraffin-embedded human kidney using PSMD12 antibody at dilution of 1:100 (40x lens).
-
Background
Component of the 26S proteasome, a multiprotein complex involved in the ATP-dependent degradation of ubiquitinated proteins. This complex plays a key role in the maintenance of protein homeostasis by removing misfolded or damaged proteins, which could impair cellular functions, and by removing proteins whose functions are no longer required. Therefore, the proteasome participates in numerous cellular processes, including cell cycle progression, apoptosis, or DNA damage repair.
Related Products / Services
Please note: All products are "FOR RESEARCH USE ONLY AND ARE NOT INTENDED FOR DIAGNOSTIC OR THERAPEUTIC USE"
